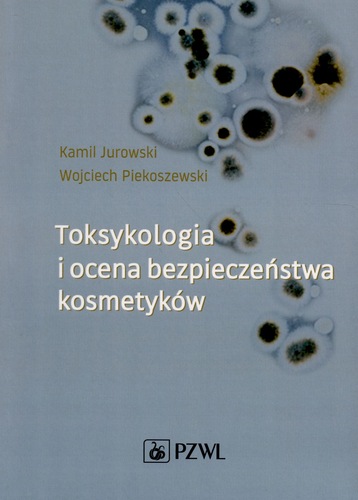
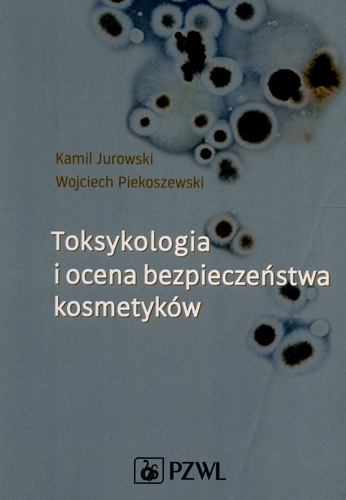

- Tytuł pełny:
- Glossary of preventive toxicology = Glossarij profilaktiĉeskoj toksikologii : Wörterbuch der präventiven Toxicologie : English-russisch-deutsch / hrsg. Peter Elstner, Peter Lüderitz
- Wydawca:
- Berlin : Verlag Tribüne
- Rok wydania:
- 1985
Książka